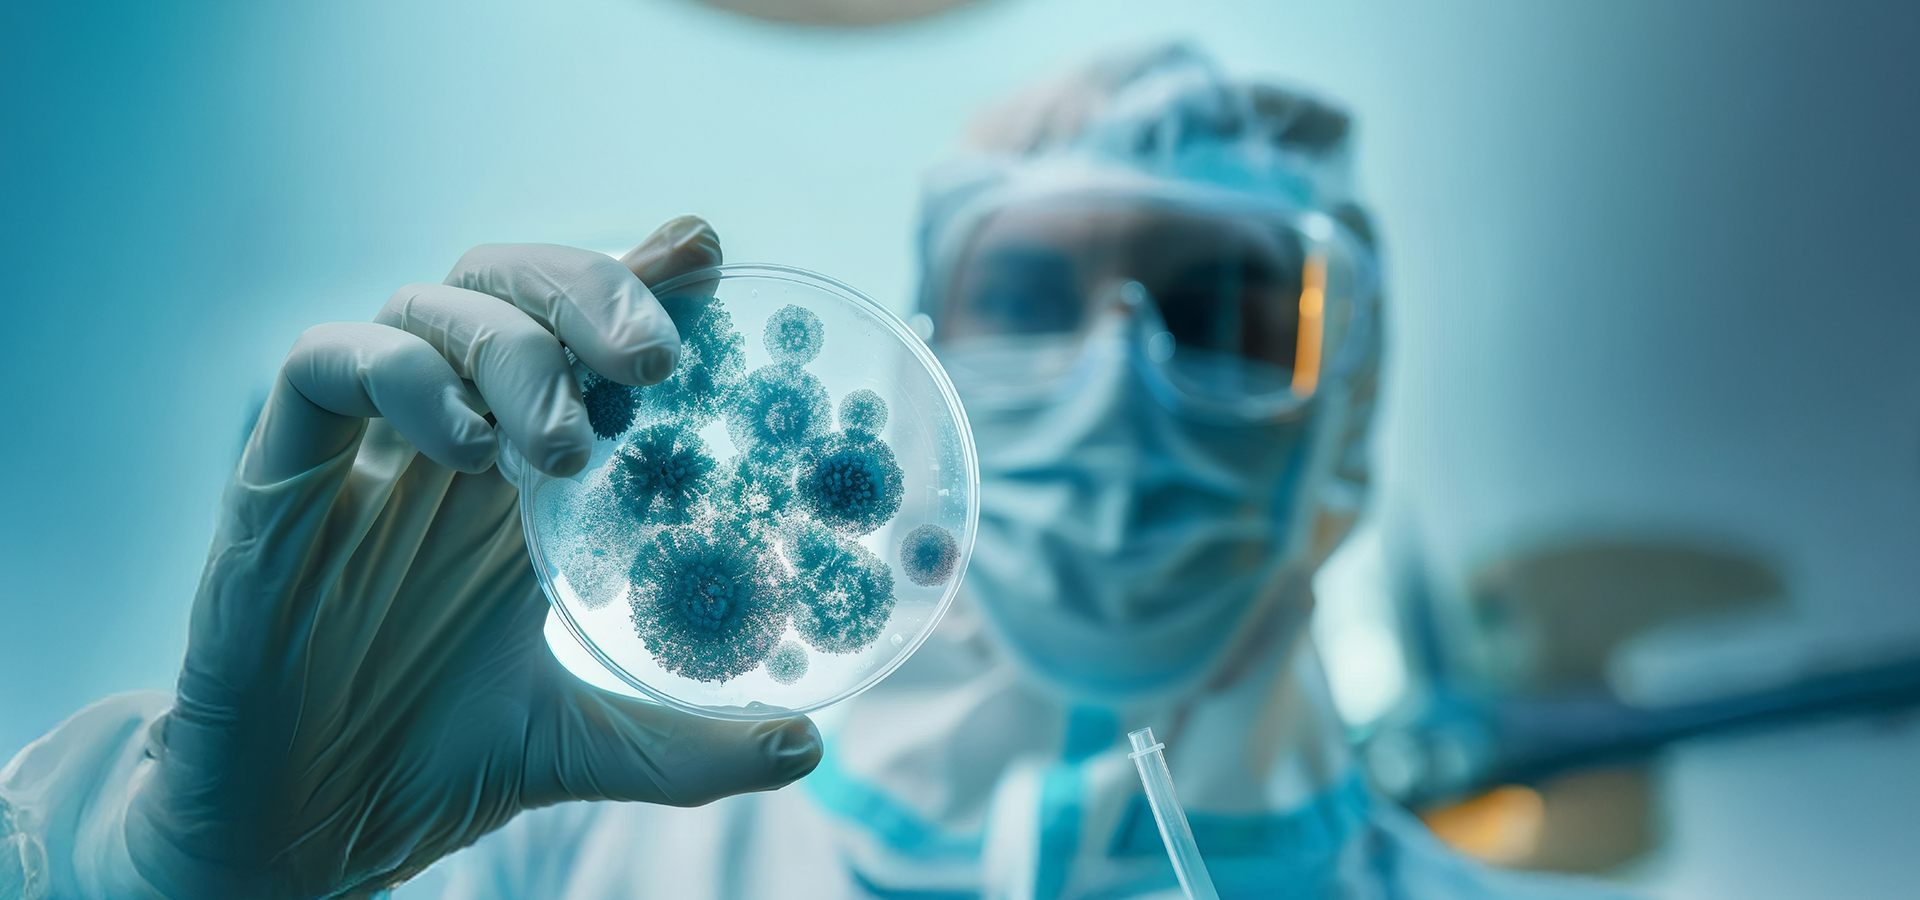
Especialista em Epidemiologia

Especialista em Epidemiologia
duracao.semestre.90horas
90 horas ()
Competências:
Doenças infecciosas
Políticas públicas e epidemiologia
Informação em saúde e processos avaliativos
duracao.semestre.90horas
Pular para as informações do produto
Preencha seus dados
Preço normal
Preço promocional
R$ 330,00
por
R$
145,20
/mês
Diferenciais do Curso
Formação focada no diagnóstico, prevenção e controle de doenças infecciosas com apoio em epidemiologia e gestão de dados em saúde.
Certificado
Todos os cursos possuem certificado de conclusão.
Controle de doenças
Análise de Dados
Vigilância em Saúde
Áreas de atuação
Conheça mais sobre os cursos
Áreas de Atuação
O que você vai aprender
Pro